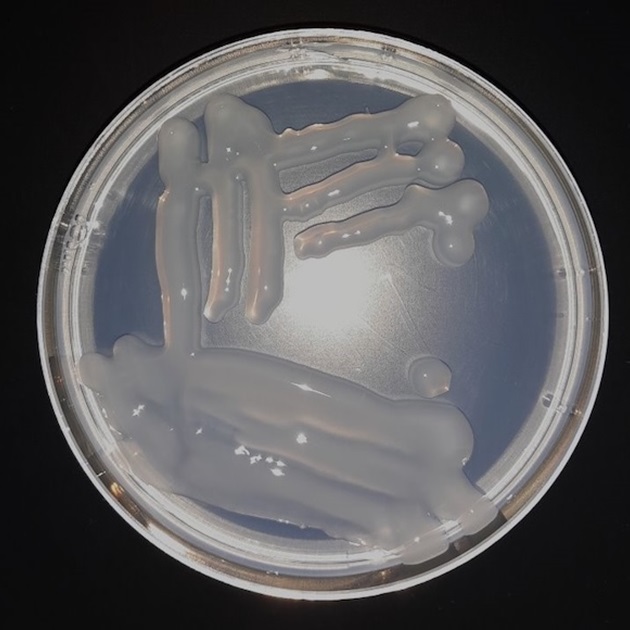
Mesorhizobium ciceri plate

In 2025, an international rhizobium strain collection network was established between Legume Rhizobium Sciences curators of Murdoch University’s International Legume Inoculant Genebank and collection curators in Brazil (Embrapa Soja and Embrapa Agrobiologia), Finland (HAMBI) and South Africa (South African Rhizobium Culture Collection, (SARCC).
The purpose of the International Rhizobia and Rhizobacteria Biobank Network (IRRBN) is to link international working collections of rhizobia. The IRRBN will facilitate ongoing best-practice strategies for rhizobial strain collection curation, management and maintenance; sharing of strains and knowledge within the network; and provide opportunities for scientific collaboration between members.

What are rhizobia?
Legumes form a symbiotic association with a group of soil bacteria called rhizobia. The rhizobia form nodules on legume roots (and rarely on stems) and fix atmospheric nitrogen into plant-available nitrogen. In farming systems, this biological nitrogen fixation reduces reliance on industrially synthesised fertilisers. The agricultural practice of legume inoculation using targeted strains of rhizobia was first established in the 1890s in Europe and the United States.
Over the past 130 years, international research organisations and institutes have curated tens of thousands of rhizobia strains of agricultural and research significance into multiple genebank collections. Historically, these collections had a regional or national focus and were weighted towards particular species of rhizobia in order to target the legumes grown in that region. These collections continue to supply the inoculant rhizobia that provide much of the nitrogen fixed by pulse, oilseed, pasture and forage legumes for international agriculture, valued at up to $12 billion annually.
Individually and collectively, these international rhizobia strain collections are an irreplaceable, priceless resource. Many historical collections are being lost, and while numerous rhizobia continue to be collected globally, they are not appropriately stored and preserved.

Contact
For further information on the IRRBN or its members, contact IRRBN Chair Dr Jason Terpolilli
IRRBN members
Chair
Dr Jason Terpolilli
International Legume Inoculant Genebank (ILIG), Legume Rhizobium Sciences (LRS) and Murdoch University
Perth, Western Australia
Dr Graham O’Hara
International Legume Inoculant Genebank (ILIG), LRS and Murdoch University
Perth, Western Australia
Dr Ahmed Idris Hassen
South African Rhizobium Culture Collection (SARCC), ARC-Plant Health and Protection
Pretoria, South Africa
Dr Mariangela Hungria
Embrapa Soja, Embrapa Soja Microbiological Resource Center
Londrina, Paraná, Brazil
Executive Officer
Helen Shortland-Jones
International Legume Inoculant Genebank (ILIG), Legume Rhizobium Sciences (LRS) and Murdoch University
Perth, Western Australia
Dr Jerri Zilli
Embrapa Agrobiologia, Johanna Dobereiner Biological Resource Center (CRB-JD)
Seropédica, Rio de Janeiro, Brazil
Professor Ville Friman
HAMBI Culture Collection, University of Helsinki
Helsinki, Finland
Pekka Oivanen
HAMBI Culture Collection, University of Helsinki
Helsinki, Finland
